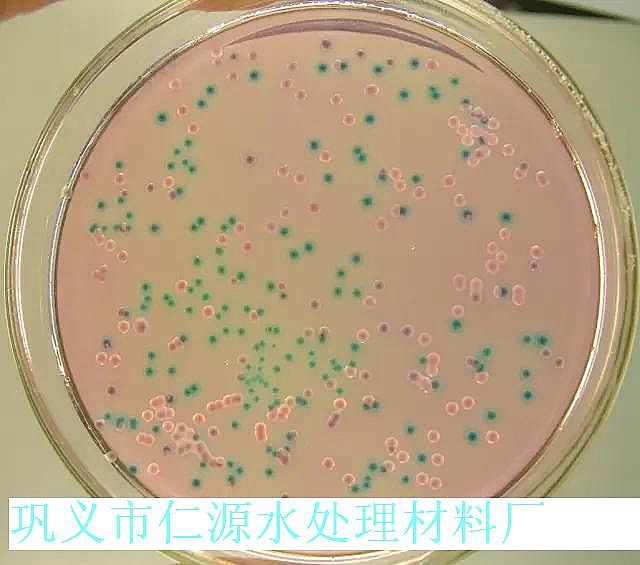

鞏義市仁源水處理材料廠
聯(lián)系人:孫經(jīng)理
手機(jī):15838253283(微信同號(hào))
電話:0371-66557686
郵箱:1813885391@qq.com
地址:河南省鞏義市工業(yè)園區(qū)
海綿鐵廠家:循環(huán)水的常見(jiàn)問(wèn)題分析及判斷(結(jié)垢,腐蝕,微生物)
海綿鐵濾料(除氧劑)價(jià)格,海綿鐵濾料(除氧劑)廠家直銷,鍋爐除氧劑,海綿鐵濾料(除氧劑)規(guī)格
循環(huán)水系統(tǒng)的降溫是依靠冷卻塔的蒸發(fā)作用帶走熱量的。由于水的蒸發(fā),各種無(wú)機(jī)離子和有機(jī)物質(zhì)濃度增加,即濃縮現(xiàn)象。濃縮會(huì)改變水的性質(zhì),加重水的結(jié)垢和腐蝕傾向;在冷卻塔中,水在與空氣接觸中會(huì)失去部分游離的二氧化碳,使pH值升高,加大結(jié)垢傾向;另外空氣中的氧進(jìn)入水中,增加了水的腐蝕傾向;水在與空氣接觸過(guò)程中,還會(huì)將空氣中的灰塵、微生物、污染氣體(如二氧化硫、硫化氫和氨等)或昆蟲等帶入水系統(tǒng),引起水質(zhì)污染,產(chǎn)生細(xì)菌和藻類繁殖。

每一個(gè)循環(huán)冷卻水系統(tǒng)無(wú)論其設(shè)備材質(zhì)如何,設(shè)備類型如何,也不論其補(bǔ)充水源如何,都會(huì)受沉積物的析出與附著、設(shè)備腐蝕和微生物滋生及黏泥問(wèn)題的困擾。它們會(huì)威脅和破壞企業(yè)長(zhǎng)周期地安全生產(chǎn),甚至造成經(jīng)濟(jì)損失,因此決不能掉以輕心。
1.沉積物的析出與附著—水垢與污垢
1.1 水垢
水中溶解有各種鹽類,如重碳酸鹽、碳酸鹽、硫酸鹽、氯化物、硅酸鹽,其中以溶解的重碳酸鹽如Ca(HCO3)2、Mg(HCO3)2最不穩(wěn)定,受熱或CO2溢出,反應(yīng)向右進(jìn)行,即分解生成碳酸鹽。
Ca(HCO3)2 →CaCO3↓+ H2O + CO2↑
常見(jiàn)的水垢組成為:碳酸鈣、硫酸鈣、磷酸鈣、鎂鹽、硅酸鹽。

1.2 污垢
油污、腐蝕產(chǎn)物、顆粒細(xì)小的泥砂、不溶性鹽類的泥狀物、膠狀氫氧化物、特別是菌藻的尸體及其黏性分泌物是污垢的主要組成部分。
在流速較慢的部位污垢沉積最多。它們是引起垢下腐蝕的主要原因,也是某些細(xì)菌如厭氧菌生存和繁殖的溫床。
1.3水垢與污垢的危害
①降低傳熱效率或傳熱不均。設(shè)備腐蝕(垢下腐蝕)。
②增加管線輸送壓力差及電力消耗。降低緩蝕劑性能。
③增加工廠非計(jì)劃性停車。甚至?xí)斐赡承┰O(shè)備的直接報(bào)廢。
2.腐蝕機(jī)理及危害
循環(huán)水的腐蝕主要為電化學(xué)腐蝕,也就是鋼材與水中氧氣作用而腐蝕;當(dāng)微生物繁殖時(shí),其微生物的分泌物與冷卻水中有機(jī)物、無(wú)機(jī)物聚積而形成粘泥,沉積在系統(tǒng)中時(shí),將造成沉積物下金屬腐蝕。另外,pH值、溫度、流速、大氣污染物等也是影響腐蝕的因素。
腐蝕主要危害:
①減少設(shè)備的使用壽命。增加設(shè)備維護(hù)費(fèi)用及生產(chǎn)成本。設(shè)備穿孔造成報(bào) 廢。
②資源和能源浪費(fèi)嚴(yán)重。
③引發(fā)災(zāi)難性事故。
④造成環(huán)境污染,阻礙新技術(shù)的發(fā)展。

3.微生物滋生及黏泥問(wèn)題
微生物危害在循環(huán)冷卻水系統(tǒng)中是很嚴(yán)重的,有人認(rèn)為對(duì)化學(xué)處理來(lái)說(shuō),微生物控制工作可說(shuō)是“一榮俱榮,一損俱損”。國(guó)外也有文章認(rèn)為“最大的挑戰(zhàn)來(lái)自微生物繁殖”。與水垢、電化學(xué)腐蝕比起來(lái),其危害更勝一籌。微生物帶給系統(tǒng)的危害不外乎污垢和腐蝕。表現(xiàn)出來(lái)時(shí),往往和水垢,電化學(xué)腐蝕的危害混合在一起。微生物粘泥是以微生物菌體及其粘結(jié)在一起的粘性物質(zhì)(多糖類、蛋白質(zhì)等)為主體組成。敞開式循環(huán)冷卻水系統(tǒng)中,由產(chǎn)粘泥細(xì)菌引起的故障為最多,其次則是由藻類、霉菌(絲狀菌)、球衣細(xì)菌(絲狀細(xì)菌)引起的故障。
3.1 各種微生物的生長(zhǎng)環(huán)境
絕大多數(shù)水中微生物的生長(zhǎng)溫度在20~40℃;pH值5~9,部分微生物即使在溫度70℃;pH值2~3之間也適宜繁殖。因此,在每個(gè)循環(huán)冷卻水系統(tǒng)都有微生物的活動(dòng)滋生。
3.2 微生物滋生及黏泥主要危害:
①形成污垢沉積物,降低冷卻水的冷卻效果,增加能耗并影響正常生產(chǎn)。
②大量的黏泥將堵塞換熱器(冷卻器)中冷卻水的通道,從而使冷卻水無(wú)法工作;少量的黏泥則減少冷卻水通道的截面積,從而降低冷卻水的流量和冷卻效果,增加泵壓。
③ 黏泥集積在冷卻塔填料的表面或填料間,堵塞了冷卻水的通過(guò),降低冷卻塔的冷卻效果。
④ 黏泥覆蓋在換熱器內(nèi)的金屬表面,阻止緩蝕劑與阻垢劑到達(dá)金屬表面發(fā)揮其緩蝕與阻垢作用,阻止殺生劑殺滅黏泥中和黏泥下的微生物,降低這些藥劑的功效,加劇了垢下腐蝕。
⑤ 黏泥覆蓋在金屬表面,形成差異腐蝕電池,引起這些金屬設(shè)備的腐蝕。
結(jié)垢、腐蝕、微生物問(wèn)題是制約循環(huán)冷卻水系統(tǒng)正常運(yùn)行的三大危害,通過(guò)以上的分析可以看出,這三個(gè)問(wèn)題之間相互影響,因此,循環(huán)冷卻水系統(tǒng)的化學(xué)處理方案必定是一個(gè)綜合的方案,一套優(yōu)秀的循環(huán)冷卻水處理方案必須同時(shí)能夠做到:良好的阻垢、緩蝕效果,卓有成效的殺生滅菌處理。
更多水處理材料詳情點(diǎn)擊:http://m.tradester.cn/